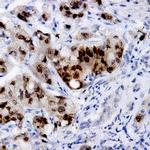
IKK-alpha Antibody in Immunohistochemistry (Paraffin) (IHC (P))
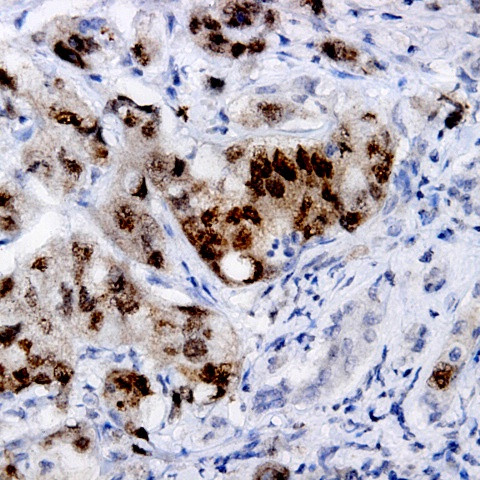
IKK-alpha Antibody in Immunohistochemistry (Paraffin) (IHC (P))

Search
AbboMax
IKK-alpha Polyclonal Antibody
{{$productOrderCtrl.translations['antibody.pdp.commerceCard.promotion.promotions']}}
{{$productOrderCtrl.translations['antibody.pdp.commerceCard.promotion.viewpromo']}}
{{$productOrderCtrl.translations['antibody.pdp.commerceCard.promotion.promocode']}}: {{promo.promoCode}} {{promo.promoTitle}} {{promo.promoDescription}}. {{$productOrderCtrl.translations['antibody.pdp.commerceCard.promotion.learnmore']}}
图: 1 / 1
IKK-alpha Antibody (601-100ABBOMAX) in IHC (P)
产品信息
601-100ABBOMAX
种属反应
宿主/亚型
分类
类型
抗原
偶联物
形式
浓度
规格
纯化类型
保存液
内含物
保存条件
运输条件
产品详细信息
Positive control: Human ovarian cancer
Cellular location: Cytoplasm, Nucleus.
靶标信息
CHUK (IKK alpha) is a serine/threonine kinase involved in signal transduction and cellular communication. It belongs to the cytokine activated protein complex that is an inhibitor of the NF-kappa B complex. IKK alpha along with IKK beta and a regulatory protein NEMO (IKK gamma) phosphorylates IkB proteins which targets the later for ubiquitin mediated degradation. It is involved with several cellular processes with extensive studies on its role in inflammation and cell survival.
仅用于科研。不用于诊断过程。未经明确授权不得转售。
篇参考文献 (0)
生物信息学
蛋白别名: Conserved helix-loop-helix ubiquitous kinase; EC 2.7.11.10; FLJ40509; I-kappa-B kinase 1; I-kappa-B kinase 2; I-kappa-B kinase alpha; I-kappa-B kinase-alpha; ikappaB kinase; IkB kinase alpha subunit; IKBKB; IKK-1; IKK-a kinase; IKK-B; IKK-beta; IKK2; IKKB; Inhibitor of nuclear factor kappa-B kinase subunit alpha; kinase beta; MGC131801; NFKBIKA; NFKBIKB; Nuclear factor NF-kappa-B inhibitor kinase alpha; Nuclear factor NFkappaB inhibitor kinase alpha; protein kinase; TCF-16; Transcription factor 16
基因别名: BPS2; CHUK; IKBKA; IKK-1; IKK-alpha; IKK1; IKKA; NFKBIKA; TCF16
UniProt ID: (Human) O15111
Entrez Gene ID: (Human) 1147